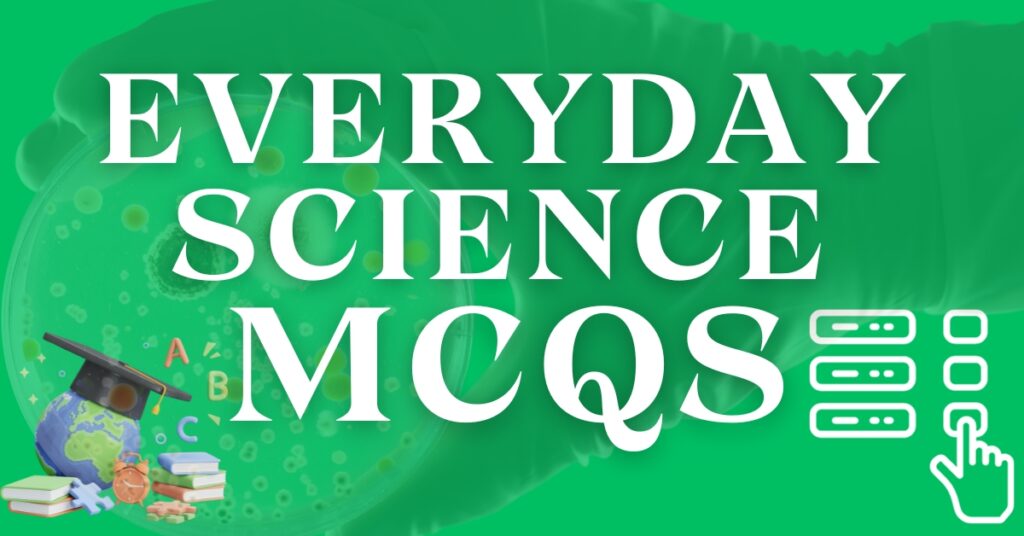
Everyday Science MCQs - EDS MCQs

Everyday Science MCQs is a significant component of competitive exams like PPSC, FPSC, NTS, CSS MPT, PMS GK and other exams. The worth of the EDS portion in these exams cannot be overstated. Because it covers 5 to 7 marks in the one paper and sometimes it exceeded from 7 (depending on the testing agency). On the other hand, among all these exams this part of the paper is the favorite for FPSC. This section includes questions related to Vitamins, Human Body, Astronomy, SI units, About Plants, Inventions and Discoveries, Biology, Physics, Atmospheric Studies and Chemistry. Here you will find most repeated and most important questions of general science.
Father of Various Branches
| Branches | Father |
|---|---|
| Father of Science & Zoology | Aristotle |
| Father of Virology | Wendell Meredith Stanley |
| Father of Fermentation | Louis Pasteur ForMemRs |
| Father of Cytology | Robert Hooke |
| Father of Medicine | Hippocrates |
| Father of DNA Fingerprinting | Sir Alec Jeffreys |
| Father of Genetics | Gregor Mendel |
| Father of Antibiotics | Selman Waksman |
| Father of Botany | Theophrastus |
| Father of Taxonomy | Carl Linnaeus |
| Elements in Earth Crust | |
|---|---|
| Oxygen | 46.60% |
| Silicon | 27.7% |
| Aluminum | 8.1% |
| Iron | 5% |
| Hydrogen | 0.14% |
| Sodium | 2.83% |
| Air Composition in Earth Atmosphere | |
|---|---|
| Nitrogen | 78.08% |
| Oxygen | 20.94% |
| Argon | 0.934% |
| Carbon Dioxide | 0.04% |
| Other Gases | Methane, Nitrous Oxide, Ozone |
Here are some of the most repeated mcqs that are asked related to the elements and their chemical formulas.
| Chemical Formulas | |
|---|---|
| Washing Soda | Na2CO3 |
| Baking Soda | NaHCO3 Sodium Bicarbonate |
| Phosphoric Acid | H3PO4 |
| Vinegar | CH3COOH |
| Bleaching Powder | CaOCl2 |
| Limestone | CaCO3 |
| Chloroform | CHCl3 |
| Sand | SiO2 Silica Silicon Dioxide |
| Plaster of Paris | CaSO4.1/2H2O |
| Caustic Soda | NaOH |
| Marble | CaCO3 |
| Gypsum | CaSO4.2H2O |
| Caustic Potash | KOH |
Father of Some Subjects / Sciences
| Subjects | Father |
|---|---|
| Father of Geometry | Euclid |
| Father of Geography | Eratosthenes |
| Father of Economics | Adam Smith |
| Father of Sociology | Auguste Comte |
| Father of Physiology | Claude Bernard |
| Father of Biotechnology | Károly Ereky |
| Father of Nuclear Chemistry | Otto Hahn |
| Father of Modern Medicine | Hippocrates of Kos |
| Father of Electronics | Michael Faraday |
| Father of Homeopathy | Samuel Hahnemann |
| Father of History | Herodotus |
| Father of Architecture | Imhotep |
| Father of Nanotechnology | Richard Feynman |
| Father of Psychology | Wilhelm Wundt |
Substances and Acid Present
Also check the substances and the acid present in them.
| Substance | Acid |
|---|---|
| Lemon | Citric Acid |
| Tea | Tannic Acid |
| Fats | Palmitic Acid Stearic Acid |
| Red Ants | Formic Acid |
| Olive Oil | Oleic Acid |
| Apples | Malic Acid |
| Vinegar | Acetic Acid |
| Tomato | Oxalic Acid |
| Curd | Lactic Acid |
| Gastric Juice | Hydrochloric Acid (HCl) |
| Orange | Citric Acid |
Everyday Science MCQs
Which of the following gas does a photocopy machine produce?
a. Helium
b. Ozone
c. Carbon Monoxide
d. Neon
Force per unit area is called?
a. Pressure
b. Energy
c. Power
d. Work
SI unit of pressure is?
a. Pascal
b. Newton
c. Joule
d. Watt
Substances producing H+ ions are?
a. Acids
b. Bases
c. Salts
d. Metals
Substances producing OH- ions are?
a. Bases
b. Acids
c. Salts
d. Non-metals
The least count of a Vernier caliper is?
a. 0.01 mm
b. 0.1 mm
c. 1.1 mm
d. 0.001 mm
pH of pure water is?
a. 7
b. 5
c. 2
d. 14
What is the total blood volume in an adult?
a. 5-6 liters
b. 3-4 liters
c. 8-10 liters
d. 10-12 liters
Increase in size due to heat is?
a. Thermal expansion
b. Contraction
c. Cooling
d. Freezing
Decrease in size due to cooling is?
a. Thermal contraction
b. Expansion
c. Heating
d. Melting
Convex lens is used for?
a. Long sight
b. Short sight
c. Blindness
d. Astigmatism
Which of the following has maximum water content:
a. Fruits
b. Sauces
c. Vegetables
d. Salts
Concave lens is used for?
a. Short sight
b. Long sight
c. Blindness
d. Astigmatism
AC stands for?
a. Alternating current
b. Active current
c. Analog current
d. Auto current
Digestion of food is completed in the:
a. Stomach
b. Small intestine
c. Liver
d. Large intestine
Which type of coal is used on mega scale?
a. Anthracite
b. Lignite
c. Bituminous
d. None of these
Tibia is a bone found in which part of the body?
a. Ear
b. Hand
c. Leg
d. Ribs
From which substance cell wall of plant cells are formed:
a. Carbs
b. Cellulose
c. Protein
d. None of these
What is the chemical symbol for gold?
a. Au
b. Ag
c. Fe
d. Cu
Pasteurization of milk depends on which factor:
a. Time
b. Temperature
c. Quantity
d. Both a & b
What is the name of the gas that comprises the majority of the Earth’s atmosphere?
a. Nitrogen
b. Helium
c. Argon
d. Hydrogen
How many major/largest types of climate zones around the globe?
a. 02
b. 03
c. 09
d. 11
What is the largest organ in the human body?
a. Liver
b. Skin
c. Heart
d. Lungs
Cerebrum the largest part of the brain controls _____ ?
a. Thoughts
b. Blood Circulation
c. Sleep
d. None of these
Diamond is an allotropic form of:
a. Hydrogen
b. Carbon
c. Oxygen
d. All of these
Which of the following gases is responsible in maintaining atmospheric temperature on Earth?
a. Nitrous Oxide
b. Ozone
c. Chlorofluorocarbons
d. Carbon Dioxide
Which of the following is not a monosaccharide?
a. Lactose
b. Fructose
c. Glucose
d. All of these
What is the largest mammal in the world?
a. Blue Whale
b. African Elephant
c. Giraffe
d. Hippopotamus
Hemoglobin is soluble in?
a. Salt
b. Water
c. Methane
d. None of these
The adult human body has a total of how many bones?
a. 206
b. 214
c. 180
d. 300
What is the chemical symbol for water?
a. H2O
b. CO2
c. O2
d. C2H4
The smallest bone in the human body which is named as stapes is found in:
a. Ear
b. Face
c. Leg
d. Nose
What is the name of the process that turns liquid into gas?
a. Condensation
b. Evaporation
c. Sublimation
d. Deposition
Which planet is known as the “Red Planet”?
a. Venus
b. Mars
c. Jupiter
d. Saturn
Which planet is known as the “Blue Planet”?
a. Saturn
b. Venus
c. Earth
d. Jupiter
Continue reading EDS MCQs
Hottest planet in the solar system:
a. Mars
b. Venus
c. Neptune
d. Mercury
Smallest planet in solar system:
a. Mercury
b. Mars
c. Earth
d. Venus
Identify the smallest planet in our solar system among the following:
a. Mars
b. Earth
c. Jupiter
d. Mercury
Identify the person who discovered vitamins?
a. Martin Cooper
b. Alexander Fleming
c. Casimir Funk
d. None of these
In which part of the human body is the urine produced?
a. Liver
b. Stomach
c. Kidney
d. None of these
What is the height of Ozone layer from the earth in miles?
a. 8-15 miles
b. 5-17 miles
c. 9-18 miles
d. None of these
In Kilometer it is 15 to 30 km.
Study of Spellings is famously known as _____ ?
a. Calligraphy
b. Orthography
c. Anatomy
d. None of these
Study of Signs/Symbols is commonly known as _____ ?
a. Calligraphy
b. Semiotics (Semiology)
c. Anatomy
d. None of these